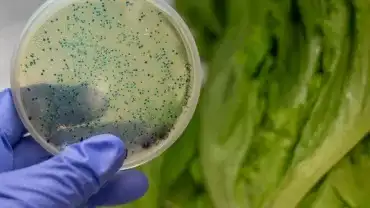
Paczkowane sałaty - Czy to dobry pomysł?

Szkodliwe produkty
Czy wiesz, że nie wszystkie produkty dostępne w sklepach są bezpieczne dla zdrowia? Co jakiś czas dowiadujemy się o kontrolach Sanepidu i wycofanych ze sprzedaży artykułach. Zdarza się to zarówno w przypadku leków i żywności, przyborów kuchennych, jak i wielu innych rodzajów produktów.
Rakotwórcze wnętrza samochodów
Większość z nas dobrze zna ten charakterystyczny zapach nowego auta, a sporo osób wręcz go uwielbia! Niestety, prawda jest taka, że ten zapach wywodzi się z toksycznych substancji zawartych w elementach wyposażenia wnętrza samochodu, których opary… Czytaj więcejZapachy, za które słono płacisz własnym zdrowiem
Rzekomo przyjemny zapach dla naszego nosa, wcale nie musi oznaczać przyjemności dla całego naszego organizmu, a może się nawet zdarzyć, że składniki pachnidła wyrządzą nam niemałą krzywdę. Jak to możliwe? Otóż każda syntetyczna kompozycja zapachowa… Czytaj więcejSklepy sprzedają nam nieprzebadane mięso z chorych krów!
Jeden z dziennikarzy "Superwizjera" wcielił się w poszukującego pracy rzeźnika. Dziennikarz został zatrudniony w ubojni połączonej z zakładem przetwórstwa mięsa, a po dwóch tygodniach trafił na nocną zmianę, która zajmuje się ubojem krów Czytaj więcejJedzenie na wynos - Uwaga na rakotwórcze pojemniki i opakowania!
Zapewne zdarzyło Ci się niejednokrotnie zamówić ciepłe danie na wynos, które zapakowano w styropianowy pojemnik, lub pić gorącą kawę z polistyrenowego kubka. Styropianowe pojemniki na żywność, polistyrenowe kubki i talerzyki są w naszym kraju bardzo… Czytaj więcejSyrop glukozowo-fruktozowy skraca życie! Te produkty nas zabijają!
Pomimo nieustannych postępów ludzkości w niemalże każdej dziedzinie nauki, nasze życie wcale nie przedłuża się proporcjonalnie do osiąganego poziomu wiedzy. Już kilka ładnych dekad temu tendencje, zarówno naszego życia do stopniowego wydłużania się… Czytaj więcejMięso z Lidlla pełne azotanów?
Czemu warto kontrolować ilość azotanów w żywności i na co przeważnie wskazuje ich nadmiar? Otóż stężenie tych substancji w produktach spożywczych jest dość precyzyjnym wskaźnikiem ich jakości Czytaj więcejPłatki śniadaniowe powodują raka? Przecież miały być zdrowe!
Od około 7 dekad, ilość produkowanych rocznie pestycydów nieustannie wzrasta, przy czym choroby cywilizacyjne stają się coraz bardziej powszechne i odczuwalne. Radykalna zmiana naszej postawy wobec tych okoliczności, to jedyne co może powstrzymać… Czytaj więcejSoja szkodzi zdrowiu, a producenci ukrywają prawdę!
W związku z panującą dziś modą na zdrowe odżywianie, weganizm i wegetarianizm, spożywcze produkty sojowe cieszą się obecnie dużym uznaniem, szczególnie wśród osób nie spożywających mięsa Czytaj więcejPaczkowane sałaty pełne patogenów! Zjadł ślimaka i umarł!
Często robimy zakupy w pośpiechu, a po zakupowym rajdzie, śpiesząc się przygotowujemy posiłek. Działając pod silną presją czasu, bezgranicznie ufamy informacjom zamieszczonym na opakowaniach produktów, które wrzucamy do wózka! Czy to z lenistwa,… Czytaj więcejNajnowsze badania: olej rzepakowy może poważnie szkodzić zdrowiu!
Bardzo popularny w Polsce olej rzepakowy jest spożywczym olejem roślinnym wytwarzanym z rzepaku. W związku z większą produkcją tego oleju w przeliczeniu na hektar powierzchni rolnej w porównaniu z pozostałymi roślinami oleistymi, niemalże we… Czytaj więcej10 najbardziej szkodliwych produktów spożywczych, których należy unikać w diecie
W świetle przerażających danych statystycznych dotyczących otyłości, cukrzycy i chorób serca, staje się jasne, że współczesny styl życia odbija swoje piętno na naszym zdrowiu. Mając łatwy dostęp do ogromnej ilości przeróżnych produktów spożywczych,… Czytaj więcejJadasz topione serki? Oto co Ci grozi!
Sery topione cieszą się w Polsce ogromną popularnością. Chętnie je kupujemy nie tylko dlatego, że przeważnie świetnie smakują, ale również z powodów praktycznych, takich jak niewygórowana cena, długa przydatność do spożycia i możliwość wygodnego… Czytaj więcej